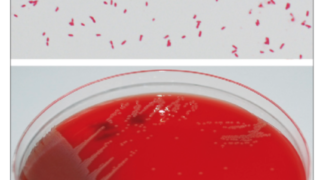

ポイント
- 抗がん剤、免疫抑制薬を投与する前はB型肝炎の感染状況を把握する
- B型肝炎の血清学的状態と薬剤によってリスクが異なることを把握する
- リスクに応じて予防的治療を考慮する
〈概念〉
B型肝炎は免疫抑制薬や抗がん剤によって既感染患者に対して再活性化を起こすことがあります。
今回他院で濾胞性リンパ腫に対してオビヌツズマブ(抗CD20モノクローナル抗体)で維持療法中の方が入院となり、HBs抗原陰性・HBc抗体陽性・HBs抗体陽性となったので再活性化のリスク・エンテカビルの投与について話題になったので簡単に勉強しました。

再活性化の定義
1 Log copy/mL以上の血清HBV-DNAの上昇
再活性化のリスク
化学療法、固形臓器移植、造血幹細胞移植、免疫抑制薬の使用
リスクとなる薬剤
グルココルチコイド、細胞傷害性抗がん剤(特にアントラサイクリン系)、生物学的製剤(抗CD20モノクローナル抗体、抗TNFα抗体、抗CD52抗体など)

〈リスク分類〉
very high risk >20%
HBs抗原陽性+ 抗CD20抗体 or 造血幹細胞移植 or アントラサイクリン系抗がん剤
high risk 11~20%
HBs抗原陽性+ PSL≧20mg 4週間以上 or 抗CD52抗体(アレムツズマブ)
HBs抗原陰性HBc抗体陽性+ 抗CD20抗体
moderate risk 1-10%
HBs抗原陽性+ ステロイドを用いない細胞傷害性抗がん剤 or 抗TNFα抗体 or 固形臓器移植後の免疫抑制薬
Low risk <1% HBs抗原陽性+ メトトレキサート or アザチオプリン HBs抗原陰性HBc抗体陽性+ PSL>20mg or 抗CD52抗体(アレムツズマブ)
Very low risk
HBs抗原陰性HBc抗体陽性+ ステロイドを用いない細胞傷害性抗がん剤 or 抗TNFα抗体 or メトトレキサート or アザチオプリン
Uncertain risk
HBs抗原陰性HBc抗体陽性+ 固形臓器移植後の免疫抑制薬
〈予防的治療〉
moderate以上のリスクではempiricに予防的治療を開始することが推奨されています。エンテカビルもしくはテノホビルが用いられます。
Lowリスク以下ではHBV-DNA量のモニタリングが推奨。
期間は免疫抑制薬終了後少なくとも6か月、抗CD20モノクローナル抗体は場合は12か月後までが推奨されている。

本症例ではHBs抗原陰性HBc抗体陽性の患者に対して抗CD20モノクローナル抗体が使用されるので、再活性化リスクは10%以上あるhigh risk患者であり米国的にはempiricにエンテカビル投与が推奨され、日本のガイドライン的にはHBV-DNA定量を行い、その結果による対応が推奨されています。
チームで議論して、HBV-DNA定量を提出すると同時にエンテカビルを投与することになりました。
ポイント
- 抗がん剤、免疫抑制薬を投与する前はB型肝炎の感染状況を把握する
- B型肝炎の血清学的状態と薬剤によってリスクが異なることを把握する
- リスクに応じて予防的治療を考慮する
参考文献
Reddy KR; American Gastroenterological Association Institute. American Gastroenterological Association Institute guideline on the prevention and treatment of hepatitis B virus reactivation during immunosuppressive drug therapy. Gastroenterology. 2015 ;148:215-9. PMID: 25447850.
Di Bisceglie AM. Recent US Food and Drug Administration warnings on hepatitis B reactivation with immune-suppressing and anticancer drugs: just the tip of the iceberg? Hepatology. 2015 ;61:703-11. PMID: 25412906.
免疫抑制・化学療法により発症する B 型肝炎対策ガイドラインhttp://www.jsh.or.jp/files/uploads/b_shiryo3_20200716.pdf